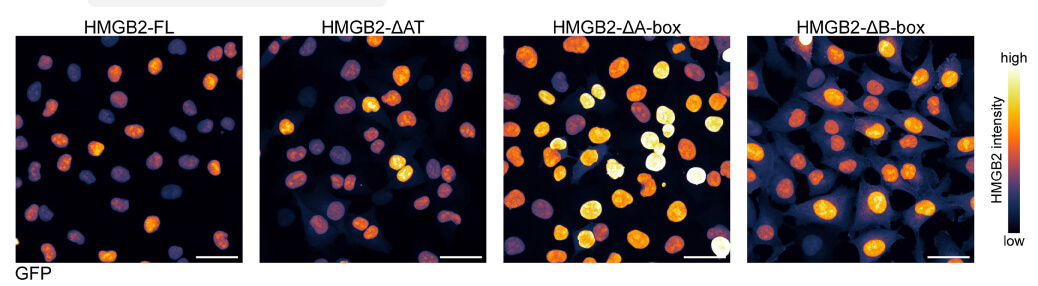

Research Highlights
Uncovering Melanoma Plasticity Under Mechanical Confinement With VitroGel®

VitroGel® Cell Invasion Assay Kit empowers researchers to model cancer invasion under physiologically relevant 3D conditions.
Category:
Invasion Assay
Subcategory:
Cell Type:
Human melanoma cells
Product Used:
VitroGel® Cell Invasion Assay Kit (IA-VHM01-1P)
Hydrogel:
VitroGel® Hydrogel Matrix (VHM01)
Team:
Miranda V. Hunter, Eshita Josh2, Sydney Bowker, Emily Montal Yilun Ma, Young Hun Kim, Zhifan Yang, Laura Tuffery, Zhuoning Li, Eric Rosiek, Alexander Browning, Reuben Moncada, Itai Yanai, Helen Byrne, Mara Monetti, Elisa de Stanchina, Pierre-Jacques Hamard, Richard P. Koche & Richard M. Hite
Institutions:
- Memorial Sloan Kettering Cancer Center
- University of Oxford
- Institute for Systems Genetics
Melanoma, a deadly form of skin cancer, is notorious for its ability to switch between growing and spreading – a phenomenon known as phenotypic plasticity. For decades, scientists have suspected that cues from the tumor’s surroundings trigger this switch, but the exact mechanism remains a mystery. Without tools that mimic the physical pressures tumors experience in the body, it was challenging to study how mechanical forces influence cancer behavior. This gap limited our understanding of how harmless skin cancers turn invasive and drug-resistant.

In this study, researchers utilized the VitroGel® Cell Invasion Assay Kit to simulate the tight spaces that melanoma cells encounter during their invasion of surrounding tissues. By confining cells within a tunable hydrogel matrix, the team discovered that physical pressure triggers a dramatic reprogramming of the cells, shifting them from a proliferative state to an invasive one. The VitroGel® system enabled precise control over mechanical stress, revealing that confined cells activate a protein called HMGB2, which remodels chromatin and promotes genes associated with invasion and drug tolerance. This hydrogel-based approach was crucial for mimicking the in vivo microenvironment and elucidating the molecular link between force and cancer aggressiveness.
This study demonstrates that mechanical confinement is a key factor in driving melanoma progression. The use of the VitroGel® Cell Invasion Assay Kit was instrumental in bridging the gap between cell culture and real-world tumor behavior, providing a physiologically relevant platform for studying invasion. By enabling researchers to replicate the mechanical forces tumors experience in the body, VitroGel® opens new avenues for studying cancer plasticity, screening anti-invasion drugs, and developing personalized treatment strategies.
PRODUCTS USED:
Discover how VitroGel® can support your cell culture research
Explore our updated resources for a concise overview of VitroGel®’s key features and application areas.
Comparison of VitroGel® vs. Animal-based ECM
Discover the 20+ advantages of VitroGel® over animal-based ECM with this comprehensive comparison on key features, operation, application, and storage conditions.
Learn MoreWhat is VitroGel® | Overview Video
Learn why VitroGel® is the leading animal-free hydrogel for 3D cell culture.
Learn MoreVitroGel® for Invasion / Migration Studies
Learn how VitroGel® provides easy and consistent cell invasion studies compared to animal-based ECMs.
Learn More





